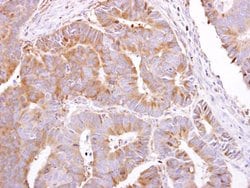

Promotional price valid on web orders only. Your contract pricing may differ. Interested in signing up for a dedicated account number?
Learn More
Learn More
Invitrogen™ PEPP2 Polyclonal Antibody


Rabbit Polyclonal Antibody
Supplier: Invitrogen™ PA532032
Description
Recommended positive controls: Jurkat. Predicted reactivity: Mouse (96%), Rat (96%). Store product as a concentrated solution. Centrifuge briefly prior to opening the vial.
Histones are basic nuclear proteins that are responsible for the nucleosome structure of the chromosomal fiber in eukaryotes. Two molecules of each of the four core histones (H2A, H2B, H3, and H4) form an octamer, around which approximately 146 bp of DNA is wrapped in repeating units, called nucleosomes. The linker histone, H1, interacts with linker DNA between nucleosomes and functions in the compaction of chromatin into higher order structures. This gene is intronless and encodes a member of the histone H3 family. Transcripts from this gene lack polyA tails but instead contain a palindromic termination element. This gene is found in the large histone gene cluster on chromosome 6.
Specifications
| PEPP2 | |
| Polyclonal | |
| Unconjugated | |
| PLEKHA5 | |
| 2810431N21Rik; AI428202; AK129423; AMH-Cre; Ayu21-9; Gt(Ayu21)9Imeg; Gt(pU21)9Imeg; KIAA1686; PEPP2; PEPP-2; PH domain-containing family A member 5; Phosphoinositol 3-phosphate-binding protein 2; phosphoinositol 3-phosphate-binding protein-2; pleckstrin homology domain containing A5; pleckstrin homology domain containing, family A member 5; pleckstrin homology domain-containing family A member 5; PLEKHA5; Tg(AMH-cre)1Flor; TRS1 | |
| Rabbit | |
| Antigen affinity chromatography | |
| RUO | |
| 54477 | |
| Store at 4°C short term. For long term storage, store at -20°C, avoiding freeze/thaw cycles. | |
| Liquid |
| Immunohistochemistry (Paraffin), Western Blot | |
| 1 mg/mL | |
| PBS with 1% BSA, 20% glycerol and 0.01% thimerosal; pH 7 | |
| Q9HAU0 | |
| PLEKHA5 | |
| Recombinant protein encompassing a sequence within the N-terminus region of human PEPP2. The exact sequence is proprietary. | |
| 100 μL | |
| Primary | |
| Human | |
| Antibody | |
| IgG |
Product Content Correction
Your input is important to us. Please complete this form to provide feedback related to the content on this product.
Product Title
Spot an opportunity for improvement?Share a Content Correction